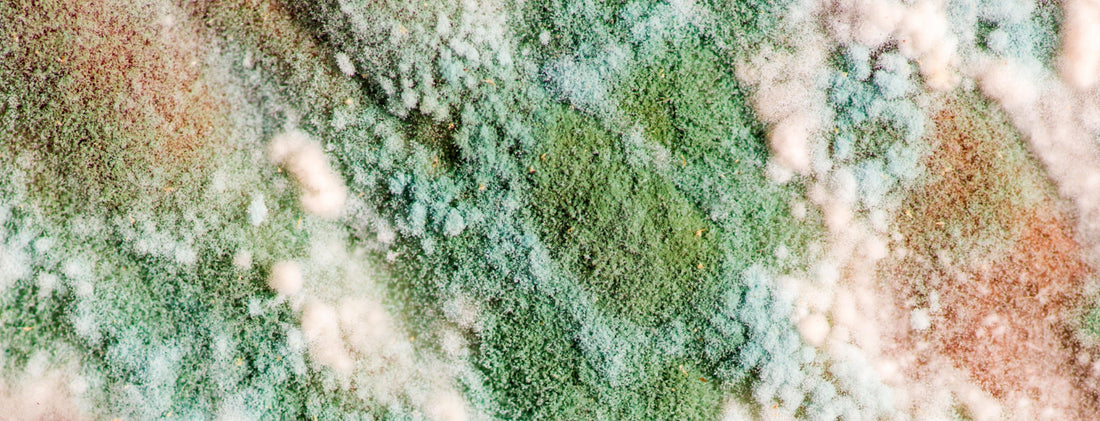
Bokashi Gone Wrong

Tell-Tale Signs Your System Isn’t Working, and What to Do About It!

Bokashi “composting” - actually a type of fermentation breakdown process - is one of the simplest (and easiest) ways for the average homeowner to deal with their kitchen wastes in a responsible manner.
- It’s quite inexpensive to get started.
- It is well-suited for compact indoor spaces.
- You can toss in almost any biodegradable kitchen waste (including meats and dairy).
- Foul smells and pest issues are very rare.
Once your bucket is full, It’s even something you can pretty much “forget” about, without any real concern, or negative repercussions.
But like almost anything in life, there are always going to be ways for a bokashi system to “go wrong”. In this article we outline some of the common problems - and solutions - relating to bokashi.
If you are completely new to bokashi, be sure to check out “Bokashi - A Simple, Effective Method for Beneficial Kitchen Waste Conversion!” to get the ball rolling!
Before we get to the “bad stuff”, it’s probably a good idea to review some of the interesting, and perfectly normal, things about bokashi that may cause some concern for those just getting started.
-
Weird “Pickle-y” Odour - The smell of a bokashi bucket can catch you off guard if you’re not familiar with it. It can be quite pungent, but the good news is that as long as it isn’t an obvious rotten smell - and is more of a sweet, somewhat “pickle-y” smell - things are definitely on the right track!
-
White Fungal Growth - It’s not unusual to assume that fungal growth on your bokashi is a bad thing (and in some cases it is), but thankfully, if what you are seeing is a moderate amount of white fungal growth - which is common once the bucket is totally full - and it's actually a good sign that an effective fermentation process has occurred! We’ll circle back to the “bad” fungi a bit further along.
NOTE: If you are seeing a really thick layer of white fungal mycelium over the contents of your bokashi bucket, it’s still “OK”, but it’s usually a sign that air is entering the system. Please remember that once your bin is full, the lid needs to be airtight and it shouldn't be opened during the 2-3 week fermentation period. - The “Unfinished” End Product - When people think of “composting”, they usually think of a rich, earthy-smelling (and looking) end product. Remember, though, bokashi isn’t actual composting - it’s an anaerobic fermentation process. As great as the process is, the product you end up with in the bucket needs to be decomposed further in a fairly aerobic environment before you can use it effectively to enrich your gardens (a topic that will be covered in more detail in the next article in this series).
OK, now that we’ve put your mind at ease about certain aspects of bokashi, it’s time to zone in on the tell-tale signs that something is actually going wrong with your system.
Lots of “Bugs” in Your System - A good quality bokashi bucket should always have a tightly fitting lid that should also be tightly closed at all times, other than when adding food deposits. This helps to ensure that the system remains mostly anaerobic, and it’s also a great way to keep out insects and other pests. If you are finding living creatures in your bucket (eg fruit flies), it almost certainly means you didn’t tightly close the lid, or that the bucket or lid are damaged in some way that’s providing access.
Make sure to always tightly close the lid (and leave the lid off as little as possible). If there is some form of breach in the bucket, you will need to either fix that (a bit of duct tape may be all you need) or get a new bucket and move everything over.
NOTE: If a fruit fly (or other pest) population gets somewhat established, they won’t thrive in the anaerobic environment, especially once the bucket is totally full and left to sit.
—
Foul Smelling Bokashi Bucket - If your bokashi bucket smells like rotten household garbage, or any other obviously-rancid rotting waste, unfortunately you will need to dispose of your bucket contents, and start again. By “dispose of” we don’t just mean toss in the garbage (unless that is really your only option).
You can still add it somewhere in your yard - just not anywhere near ornamental plants or vegetable gardens. Ideally, it should be mixed with a lot of bulky carbon-rich “browns”, and some living materials, if you have any available, and then get buried quite deep in the ground. Alternatively, if you have some sort of green bin program in your region (collection of household organic wastes) you could likely dump the bucket into your green bin.
—
Blue/Green/Black Mold Growth - Earlier we alluded to the fact that any fungal growth that isn’t white in colour is a sign that your bokashi system isn’t functioning properly. The “bad” fungi (for an effective bokashi process) will appear as your typical blue/green, or black mold growth. You may also notice foul smells as well. Once again, unfortunately this means the bucket will need to get dumped out and started over. You can follow the same disposal advice outlined in the previous section.
—
Animals in Outdoor Deposits - Unlike regular rotting kitchen wastes, the “pickled” nature of bokashi bucket contents tends to make these materials a lot less appealing to wildlife. Still, in some locations, maybe at certain times of year, you might notice some curious animals are digging in your outdoor deposits. How you prepare your “precompost” (the contents of a finished bokashi bucket) can play an important role in determining how easily local wildlife will detect your deposits in the first place.

We highly recommend mixing your precompost with a large quantity of bulky, absorbent “brown” material (eg ripped up or shredded brown cardboard), as well as some form of living material (really old, rotten fall leaves, or some regular compost).
If you can add this mix to a below-ground system (eg something like the in-ground bucket system we wrote about previously - but with no worms added yet - and then cover over with a really thick layer of additional cover bedding, that should greatly help to mask odours, but even just putting the mix in a composter and the heaping on other materials should help.
As you can see, the good news is that there really isn’t a lot that can go wrong with a bokashi system - and with a little extra care and attention during the waste addition stage (and aerobic breakdown stage, in the case of wildlife), you should be able to avoid them.
Stay tuned for the next article in our bokashi series, where we’ll delve more deeply into the nitty gritty details of converting your bokashi precompost into actual compost that can be used to add fertility and biology to your soils!
Helpful Related Resources
- Bokashi - A Simple, Effective Method for Beneficial Kitchen Waste Conversion!
- What Is “Living Material”?
- Outdoor Vermicomposting 101
- Backyard Composting - A Simple Method to Build Nutrient and Microbe Rich Compost!
Recommended Products
- Bokashi Starter Kit - Single Bin
- Premium Bokashi Starter Kit
- Bokashi Bran
- 1+ Year Supply of Bulk Bran
- Effective Microorganisms - EM